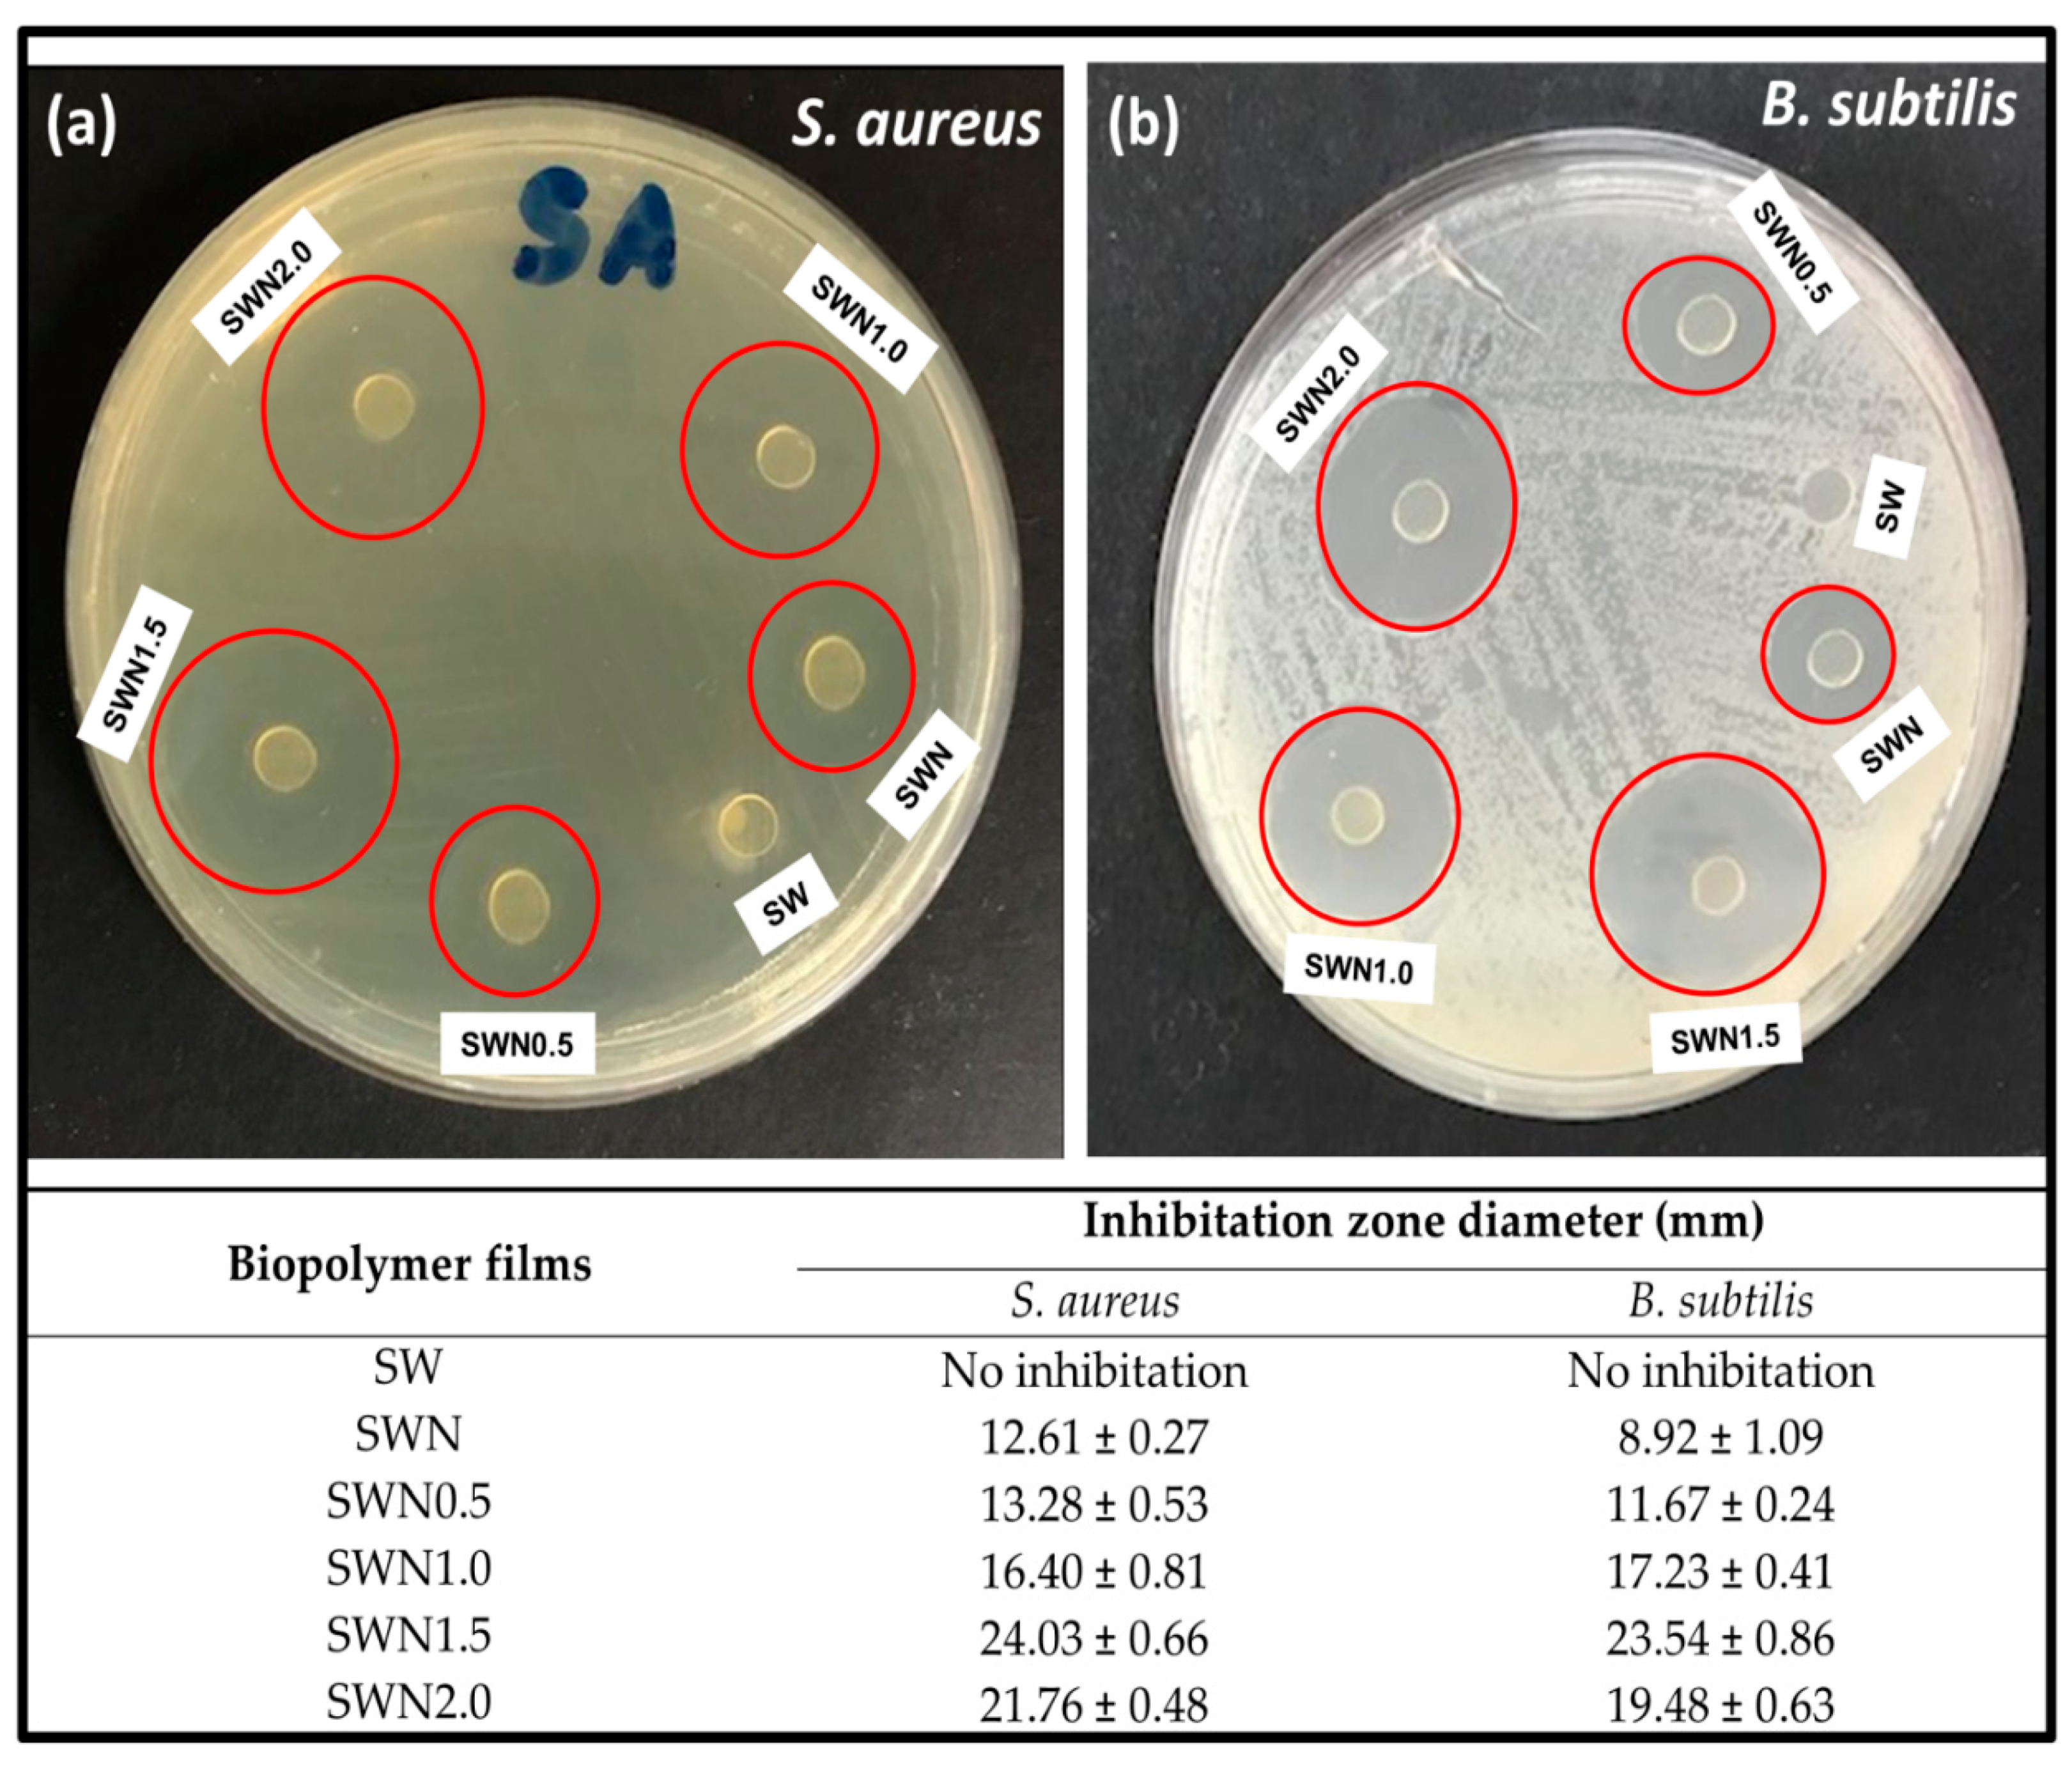
Polymers 13 01664 g008

Functional Properties of Antimicrobial Neem Leaves Extract Based Macroalgae Biofilms for Potential Use as Active Dry Packaging Applications
Abstract
1. Introduction
2. Materials and Methods
2.1. Materials
2.2. Extraction and Characterisation of Neam Leaf Exract
2.3. Preparation of Seaweed-Based Film Incorporated with Neem Leaves and Gamma Irradiated Film
2.4. Characterization of Functional Properties of Seaweed, Seaweed–Neem, and Seaweed–Neem Gamma Irradiated Film
2.5. Characterization of Storage Properties of Optimized Seaweed–Neem Gamma Irradiated Film
3. Results
3.1. Properties of Neam Leaf Exract
3.2. Functional Properties of Seaweed, Seaweed–Neem, Seaweed–Neem Gamma Irradiated Film
4. Conclusions
Author Contributions
Funding
Institutional Review Board Statement
Informed Consent Statement
Data Availability Statement
Acknowledgments
Conflicts of Interest
References
- Ghasemlou, M.; Daver, F.; Ivanova, E.P.; Adhikari, B. Polyurethanes from seed oil-based polyols: A review of synthesis, mechanical and thermal properties. Ind. Crop. Prod. 2019, 142, 111841. [Google Scholar] [CrossRef]
- Mikkonen, K.S.; Tenkanen, M. Sustainable food-packaging materials based on future biorefinery products: Xylans and mannans. Trends Food Sci. Technol. 2012, 28, 90–102. [Google Scholar] [CrossRef]
- Abdul Khalil, H.P.S.; Tehrani, M.; Davoudpour, Y.; Bhat, A.; Jawaid, M.; Hassan, A. Natural fiber reinforced poly(vinyl chloride) composites: A review. J. Reinf. Plast. Compos. 2013, 32, 330–356. [Google Scholar] [CrossRef]
- Gupta, P.; Nayak, K.K. Characteristics of protein-based biopolymer and its application. Polym. Eng. Sci. 2015, 55, 485–498. [Google Scholar] [CrossRef]
- Wang, H.; Qian, J.; Ding, F. Emerging chitosan-based films for food packaging applications. J. Agric. Food Chem. 2018, 66, 395–413. [Google Scholar] [CrossRef]
- Shahabi-Ghahfarrokhi, I.; Goudarzi, V.; Babaei-Ghazvini, A. Production of starch based biopolymer by green photochemical reaction at different UV region as a food packaging material: Physicochemical characterization. Int. J. Biol. Macromol. 2019, 122, 201–209. [Google Scholar] [CrossRef]
- Abdul Khalil, H.P.S.; Saurabh, C.K.; Adnan, A.S.; Nurul Fazita, M.R.; Syakir, M.I.; Davoudpour, Y.; Rafatullah, M.; Abdullah, C.K.; Haafiz, M.K.M.; Dungani, R. A review on chitosan-cellulose blends and nanocellulose reinforced chitosan biocomposites: Properties and their applications. Carbohydr. Polym. 2016, 150, 216–226. [Google Scholar]
- Surya, I.; Chong, E.W.N.; Abdul Khalil, H.P.S.; Funmilayo, O.G.; Abdullah, C.K.; Sri Aprilia, N.A.; Olaiya, N.G.; Lai, T.K.; Oyekanmi, A.A. Augmentation of physico-mechanical, thermal and biodegradability performances of bio-precipitated material reinforced in Eucheuma cottonii biopolymer films. J. Mater. Res. Technol. 2021, 12, 1673–1688. [Google Scholar] [CrossRef]
- Abdul Khalil, H.P.S.; Saurabh, C.K.; Tye, Y.; Lai, T.; Easa, A.; Rosamah, E.; Fazita, M.; Syakir, M.; Adnan, A.; Fizree, H. Seaweed based sustainable films and composites for food and pharmaceutical applications: A review. Renew. Sustain. Energy Rev. 2017, 77, 353–362. [Google Scholar] [CrossRef]
- Vijayan, S.R.; Santhiyagu, P.; Ramasamy, R.; Arivalagan, P.; Kumar, G.; Ethiraj, K.; Ramaswamy, B.R. Seaweeds: A resource for marine bionanotechnology. Enzym. Microb. Technol. 2016, 95, 45–57. [Google Scholar] [CrossRef]
- Balasubramanian, R.; Kim, S.S.; Lee, J. Novel synergistic transparent k-Carrageenan/Xanthan gum/Gellan gum hydrogel film: Mechanical, thermal and water barrier properties. Int. J. Biol. Macromol. 2018, 118, 561–568. [Google Scholar] [CrossRef] [PubMed]
- Doh, H.; Dunno, K.D.; Whiteside, W.S. Preparation of novel seaweed nanocomposite film from brown seaweeds Laminaria japonica and Sargassum natans. Food Hydrocoll. 2020, 105, 105744. [Google Scholar] [CrossRef]
- Rizal, S.; Abdul Khalil, H.P.S.; Oyekanmi, A.A.; Gideon, O.N.; Abdullah, C.K.; Yahya, E.B.; Alfatah, T.; Sabaruddin, F.A.; Rahman, A.A. Cotton Wastes Functionalized Biomaterials from Micro to Nano: A Cleaner Approach for a Sustainable Environmental Application. Polymers 2021, 13, 1006. [Google Scholar] [CrossRef] [PubMed]
- Hasan, M.; Lai, T.K.; Gopakumar, D.A.; Jawaid, M.; Owolabi, F.; Mistar, E.; Alfatah, T.; Noriman, N.; Haafiz, M.; Abdul Khalil, H.P.S. Micro crystalline bamboo cellulose based seaweed biodegradable composite films for sustainable packaging material. J. Polym. Environ. 2019, 27, 1602–1612. [Google Scholar] [CrossRef]
- Campos, A.d.; Marconcini, J.; Martins-Franchetti, S.; Mattoso, L. The influence of UV-C irradiation on the properties of thermoplastic starch and polycaprolactone biocomposite with sisal bleached fibers. Polym. Degrad. Stab. 2012, 97, 1948–1955. [Google Scholar] [CrossRef]
- Shahabi-Ghahfarrokhi, I.; Khodaiyan, F.; Mousavi, M.; Yousefi, H. Effect of γ-irradiation on the physical and mechanical properties of kefiran biopolymer film. Int. J. Biol. Macromol. 2015, 74, 343–350. [Google Scholar] [CrossRef]
- da Rosa, G.S.; Vanga, S.K.; Gariepy, Y.; Raghavan, V. Development of biodegradable films with improved antioxidant properties based on the addition of carrageenan containing olive leaf extract for food packaging applications. J. Polym. Environ. 2020, 28, 123–130. [Google Scholar] [CrossRef]
- Singh, S.; Gaikwad, K.K.; Lee, Y.S. Antimicrobial and antioxidant properties of polyvinyl alcohol bio composite films containing seaweed extracted cellulose nano-crystal and basil leaves extract. Int. J. Biol. Macromol. 2018, 107, 1879–1887. [Google Scholar] [CrossRef]
- Kadam, S.U.; Pankaj, S.K.; Tiwari, B.K.; Cullen, P.J.; O’Donnell, C.P. Development of biopolymer-based gelatin and casein films incorporating brown seaweed Ascophyllum nodosum extract. Food Packag. Shelf Life 2015, 6, 68–74. [Google Scholar] [CrossRef]
- Othman, L.; Sleiman, A.; Abdel-Massih, R.M. Antimicrobial activity of polyphenols and alkaloids in Middle Eastern plants. Front. Microbiol. 2019, 10, 911. [Google Scholar] [CrossRef]
- Jafarzadeh, S.; Jafari, S.M.; Salehabadi, A.; Nafchi, A.M.; Uthaya Kumar, U.S.; Abdul Khalil, H.P.S. Biodegradable green packaging with antimicrobial functions based on the bioactive compounds from tropical plants and their by-products. Trends Food Sci. Technol. 2020, 100, 262–277. [Google Scholar] [CrossRef]
- Ghasemlou, M.; Aliheidari, N.; Fahmi, R.; Shojaee-Aliabadi, S.; Keshavarz, B.; Cran, M.J.; Khaksar, R. Physical, mechanical and barrier properties of corn starch films incorporated with plant essential oils. Carbohydr. Polym. 2013, 98, 1117–1126. [Google Scholar] [CrossRef] [PubMed]
- Chen, C.; Du, Y.; Zuo, G.; Chen, F.; Liu, K.; Zhang, L. Effect of storage condition on the physico-chemical properties of corn–wheat starch/zein edible bilayer films. R. Soc. Open Sci. 2020, 7, 191777. [Google Scholar] [CrossRef]
- Al-Hashemi, Z.S.S.; Hossain, M.A. Biological activities of different neem leaf crude extracts used locally in Ayurvedic medicine. Pac. Sci. Rev. A Nat. Sci. Eng. 2016, 18, 128–131. [Google Scholar] [CrossRef]
- Brain, K.R.; Turner, T.D. The Practical Evaluation of Phytopharmaceuticals; Wright-Scientechnica: Bristol, UK, 1975; Volume 1. [Google Scholar]
- Abdel-Hameed, U.K. Delimitation of Azadirachta indica A. Juss. from Melia azedarach L. (Meliaceae Juss.) based on leaf morphology. Phyton Int. J. Exp. Bot. 2014, 83, 363–367. [Google Scholar]
- Hossain, M.A.; Shah, M.D.; Sakari, M. Gas chromatography–mass spectrometry analysis of various organic extracts of Merremia borneensis from Sabah. Asian Pac. J. Trop. Med. 2011, 4, 637–641. [Google Scholar] [CrossRef]
- Rizal, S.; Alfatah, T.; Abdul Khalil, H.P.S.; Mistar, E.M.; Abdullah, C.K.; Olaiya, F.G.; Sabaruddin, F.A.; Ikramullah; Muksin, U. Properties and Characterization of Lignin Nanoparticles Functionalized in Macroalgae Biopolymer Films. Nanomaterials 2021, 11, 637. [Google Scholar] [PubMed]
- International, A. ASTM D882-12, Standard Test Method for Tensile Properties of Thin Plastic Sheeting; ASTM International: West Conshohocken, PA, USA, 2012. [Google Scholar]
- El-Hawary, S.S.; El-Tantawy, M.E.; Rabeh, M.A.; Badr, W.K. DNA fingerprinting and botanical study of Azadirachta indica A. Juss. (neem) family Meliaceae. Beni-Suef Univ. J. Basic Appl. Sci. 2013, 2, 1–13. [Google Scholar] [CrossRef][Green Version]
- Joshi, B.; Sah, G.P.; Basnet, B.B.; Bhatt, M.R.; Sharma, D.; Subedi, K.; Janardhan, P.; Malla, R. Phytochemical extraction and antimicrobial properties of different medicinal plants: Ocimum sanctum (Tulsi), Eugenia caryophyllata (Clove), Achyranthes bidentata (Datiwan) and Azadirachta indica (Neem). J. Microbiol. Antimicrob. 2011, 3, 1–7. [Google Scholar]
- Prashanth, G.; Krishnaiah, G. Chemical composition of the leaves of Azadirachta indica Linn (Neem). Int. J. Adv. Eng. Technol. Manag. Appl. Sci. 2014, 1, 21–31. [Google Scholar]
- Karimi, E.; Jaafar, H.Z.; Ghasemzadeh, A.; Ebrahimi, M. Fatty acid composition, antioxidant and antibacterial properties of the microwave aqueous extract of three varieties of Labisia pumila Benth. Biol. Res. 2015, 48, 1–6. [Google Scholar] [CrossRef] [PubMed]
- Dineshkumar, G.; Rajakumar, R. GC-MS evaluation of bioactive molecules from the methanolic leaf extract of Azadirachta indica (A. JUSS). Asian J. Pharm. Sci. Technol. 2015, 5, 64–69. [Google Scholar]
- Kowalonek, J. Studies of chitosan/pectin complexes exposed to UV radiation. Int. J. Biol. Macromol. 2017, 103, 515–524. [Google Scholar] [CrossRef]
- Abdul Khalil, H.P.S.; Yap, S.W.; Tye, Y.Y.; Tahir, P.M.; Rizal, S.; Nurul Fazita, M.R. Effects of Corn Starch and Kappaphycus alvarezii Seaweed Blend Concentration on the Optical, Mechanical, and Water Vapor Barrier Properties of Composite Films. BioResources 2017, 13, 17. [Google Scholar] [CrossRef]
- Zhu, Z.; Kelley, M.J. IR spectroscopic investigation of the effect of deep UV irradiation on PET films. Polymer 2005, 46, 8883–8891. [Google Scholar] [CrossRef]
- Liu, Y.; Liu, Y.; Han, K.; Cai, Y.; Ma, M.; Tong, Q.; Sheng, L. Effect of nano-TiO2 on the physical, mechanical and optical properties of pullulan film. Carbohydr. Polym. 2019, 218, 95–102. [Google Scholar] [CrossRef]
- Stortz, C.A.; Cerezo, A.S. MM3 potential energy surfaces of trisaccharides. II. Carrageenan models containing 3,6-anhydro-D-galactose. Biopolymers 2003, 70, 227–239. [Google Scholar] [CrossRef]
- Gómez-Ordóñez, E.; Rupérez, P. FTIR-ATR spectroscopy as a tool for polysaccharide identification in edible brown and red seaweeds. Food Hydrocoll. 2011, 25, 1514–1520. [Google Scholar] [CrossRef]
- Resano-Goizueta, I.; Ashokan, B.K.; Trezza, T.A.; Padua, G.W. Effect of Nano-Fillers on Tensile Properties of Biopolymer Films. J. Polym. Environ. 2018, 26, 3817–3823. [Google Scholar] [CrossRef]
- Kumar, U.S.U.; Paridah, M.; Owolabi, F.T.; Gopakumar, D.A.; Rizal, S.; Amirul, A.; Rahman, A.; Alfatah, T.; Mistar, E.; Aprilia, N.S. Neem leaves extract based seaweed bio-degradable composite films with excellent antimicrobial activity for sustainable packaging material. BioResources 2019, 14, 700–713. [Google Scholar]
- Lee, S.L.; Lee, M.S.; Song, K.B. Effect of gamma-irradiation on the physicochemical properties of gluten films. Food Chem. 2005, 92, 621–625. [Google Scholar] [CrossRef]
- Din, M.I.; Sehar, R.; Hussain, Z.; Khalid, R.; Shah, A.T. Synthesis of biodegradable semolina starch plastic films reinforced with biogenically synthesized ZnO nanoparticles. Inorg. Nano Met. Chem. 2020, 1–10. [Google Scholar] [CrossRef]
- Sirviö, J.A.; Visanko, M.; Ukkola, J.; Liimatainen, H. Effect of plasticizers on the mechanical and thermomechanical properties of cellulose-based biocomposite films. Ind. Crop. Prod. 2018, 122, 513–521. [Google Scholar] [CrossRef]
- Tian, H.; Yan, J.; Rajulu, A.V.; Xiang, A.; Luo, X. Fabrication and properties of polyvinyl alcohol/starch blend films: Effect of composition and humidity. Int. J. Biol. Macromol. 2017, 96, 518–523. [Google Scholar] [CrossRef]
- BenBettaïeb, N.; Karbowiak, T.; Bornaz, S.; Debeaufort, F. Spectroscopic analyses of the influence of electron beam irradiation doses on mechanical, transport properties and microstructure of chitosan-fish gelatin blend films. Food Hydrocoll. 2015, 46, 37–51. [Google Scholar] [CrossRef]
- Madera-Santana, T.J.; Freile-Pelegrín, Y.; Encinas, J.C.; Ríos-Soberanis, C.R.; Quintana-Owen, P. Biocomposites based on poly (lactic acid) and seaweed wastes from agar extraction: Evaluation of physicochemical properties. J. Appl. Polym. Sci. 2015, 132, 42320. [Google Scholar] [CrossRef]
- Abral, H.; Basri, A.; Muhammad, F.; Fernando, Y.; Hafizulhaq, F.; Mahardika, M.; Sugiarti, E.; Sapuan, S.M.; Ilyas, R.A.; Stephane, I. A simple method for improving the properties of the sago starch films prepared by using ultrasonication treatment. Food Hydrocoll. 2019, 93, 276–283. [Google Scholar] [CrossRef]
- Gabr, M.H.; Phong, N.T.; Okubo, K.; Uzawa, K.; Kimpara, I.; Fujii, T. Thermal and mechanical properties of electrospun nano-celullose reinforced epoxy nanocomposites. Polym. Test. 2014, 37, 51–58. [Google Scholar] [CrossRef]
- Abdul Khalil, H.P.S.; Tye, Y.Y.; Ismail, Z.; Leong, J.Y.; Saurabh, C.K.; Lai, T.K.; Chong, E.W.N.; Aditiawati, P.; Tahir, P.M.; Dungani, R. Oil palm shell nanofiller in seaweed-based composite film: Mechanical, physical, and morphological properties. BioResources 2017, 12, 5996–6010. [Google Scholar] [CrossRef]
- Khan, R.A.; Dussault, D.; Salmieri, S.; Safrany, A.; Lacroix, M. Mechanical and barrier properties of carbon nanotube reinforced PCL-based composite films: Effect of gamma radiation. J. Appl. Polym. Sci. 2013, 127, 3962–3969. [Google Scholar] [CrossRef]
- Oyekanmi, A.; Saharudin, N.; Hazwan, C.; S., A.H.P.; Olaiya, N.; Abdullah, C.; Alfatah, T.; Gopakumar, D.; Pasquini, D. Improved Hydrophobicity of Macroalgae Biopolymer Film Incorporated with Kenaf Derived CNF Using Silane Coupling Agent. Molecules 2021, 26, 2254. [Google Scholar] [CrossRef]
- Kumar, S.; Boro, J.C.; Ray, D.; Mukherjee, A.; Dutta, J. Bionanocomposite films of agar incorporated with ZnO nanoparticles as an active packaging material for shelf life extension of green grape. Heliyon 2019, 5, e01867. [Google Scholar] [CrossRef] [PubMed]
- Nordin, N.; Othman, S.H.; Rashid, S.A.; Basha, R.K. Effects of glycerol and thymol on physical, mechanical, and thermal properties of corn starch films. Food Hydrocoll. 2020, 106, 105884. [Google Scholar] [CrossRef]
- Yang, W.; Qi, G.; Kenny, J.M.; Puglia, D.; Ma, P. Effect of Cellulose Nanocrystals and Lignin Nanoparticles on Mechanical, Antioxidant and Water Vapour Barrier Properties of Glutaraldehyde Crosslinked PVA Films. Polymers 2020, 12, 1364. [Google Scholar] [CrossRef] [PubMed]
- Waikar, M.R.; Raste, P.M.; Sonker, R.K.; Gupta, V.; Tomar, M.; Shirsat, M.D.; Sonkawade, R.G. Enhancement in NH3 sensing performance of ZnO thin-film via gamma-irradiation. J. Alloy. Compd. 2020, 830, 154641. [Google Scholar] [CrossRef]
- Ghaffar, A.A.; Ali, H.; Nasef, S.M.; El-Bialy, H.A. Effect of gamma radiation on the properties of crosslinked chitosan nano-composite film. J. Polym. Environ. 2018, 26, 3226–3236. [Google Scholar] [CrossRef]
- Mei, J.; Yuan, Y.; Wu, Y.; Li, Y. Characterization of edible starch–chitosan film and its application in the storage of Mongolian cheese. Int. J. Biol. Macromol. 2013, 57, 17–21. [Google Scholar] [CrossRef]
- Huang, T.; Lin, J.; Fang, Z.; Yu, W.; Li, Z.; Xu, D.; Yang, W.; Zhang, J. Preparation and characterization of irradiated kafirin-quercetin film for packaging cod (Gadus morhua) during cold storage at 4 °C. Food Bioprocess. Technol. 2020, 13, 522–532. [Google Scholar] [CrossRef]
- Osés, J.; Fernández-Pan, I.; Mendoza, M.; Maté, J.I. Stability of the mechanical properties of edible films based on whey protein isolate during storage at different relative humidity. Food Hydrocoll. 2009, 23, 125–131. [Google Scholar] [CrossRef]
- Wang, J.; Cui, Q.; Li, H.; Liu, Y. Mechanical properties and microstructure of apple peels during storage. Int. J. Food Prop. 2017, 20, 1159–1173. [Google Scholar] [CrossRef]
- Sanyang, M.L.; Sapuan, S.M.; Jawaid, M.; Ishak, M.R.; Sahari, J. Effect of plasticizer type and concentration on tensile, thermal and barrier properties of biodegradable films based on sugar palm (Arenga pinnata) starch. Polymers 2015, 7, 1106–1124. [Google Scholar] [CrossRef]
- Cano, A.I.; Cháfer, M.; Chiralt, A.; González-Martínez, C. Physical and microstructural properties of biodegradable films based on pea starch and PVA. J. Food Eng. 2015, 167, 59–64. [Google Scholar] [CrossRef]
- Fontanella, S.; Bonhomme, S.; Koutny, M.; Husarova, L.; Brusson, J.-M.; Courdavault, J.-P.; Pitteri, S.; Samuel, G.; Pichon, G.; Lemaire, J.; et al. Comparison of the biodegradability of various polyethylene films containing pro-oxidant additives. Polym. Degrad. Stab. 2010, 95, 1011–1021. [Google Scholar] [CrossRef]
- Paneru, D.P.; Rajbhandari, M. Phytochemical Analysis and Antimicrobial Activity of Smilax ovalifoliaRoxb. Ex D. Don. Nepal J. Sci. Technol. 2020, 19, 89–96. [Google Scholar] [CrossRef]
- Mehdizadeh, T.; Tajik, H.; Rohani, S.M.R.; Oromiehie, A.R. Antibacterial, antioxidant and optical properties of edible starch-chitosan composite film containing Thymus kotschyanus essential oil. In Veterinary Research Forum; Faculty of Veterinary Medicine, Urmia University: Urmia, Iran, 2012. [Google Scholar]
- Emiroğlu, Z.K.; Yemiş, G.P.; Coşkun, B.K.; Candoğan, K. Antimicrobial activity of soy edible films incorporated with thyme and oregano essential oils on fresh ground beef patties. Meat Sci. 2010, 86, 283–288. [Google Scholar] [CrossRef]
- Zengin, H.; Baysal, A.H. Antibacterial and Antioxidant Activity of Essential Oil Terpenes against Pathogenic and Spoilage-Forming Bacteria and Cell Structure-Activity Relationships Evaluated by SEM Microscopy. Molecules 2014, 19, 17773–17798. [Google Scholar] [CrossRef] [PubMed]
- Saradhajyothi, K.; Subbarao, B. Antibacterial potential of the extracts of the leaves of Azadirachta indica Linn. Not. Sci. Biol. 2011, 3, 65–69. [Google Scholar]
- Benbettaïeb, N.; Karbowiak, T.; Brachais, C.-H.; Debeaufort, F. Coupling tyrosol, quercetin or ferulic acid and electron beam irradiation to cross-link chitosan–gelatin films: A structure–function approach. Eur. Polym. J. 2015, 67, 113–127. [Google Scholar] [CrossRef]
- Han, J.; Castell-Perez, M.; Moreira, R. The influence of electron beam irradiation of antimicrobial-coated LDPE/polyamide films on antimicrobial activity and film properties. LWT Food Sci. Technol. 2007, 40, 1545–1554. [Google Scholar] [CrossRef]
- Abdollahi, M.; Alboofetileh, M.; Rezaei, M.; Behrooz, R. Comparing physico-mechanical and thermal properties of alginate nanocomposite films reinforced with organic and/or inorganic nanofillers. Food Hydrocoll. 2013, 32, 416–424. [Google Scholar] [CrossRef]
- Khalaf, H.; Sharoba, A.; El-Tanahi, H.; Morsy, M. Stability of antimicrobial activity of pullulan edible films incorporated with nanoparticles and essential oils and their impact on turkey deli meat quality. J. Food Dairy Sci. 2013, 4, 557–573. [Google Scholar] [CrossRef]

| Storage Period | TS | TM | EAB |
|---|---|---|---|
| 6 months | 43.31 ± 0.21 | 350.27 ± 0.12 | 19.22 ± 0.08 |
| 12 months | 42.24 ± 0.15 | 321.56 ± 1.14 | 19.55 ± 0.07 |
| 18 months | 41.89 ± 0.02 | 310.60 ± 1.64 | 19.98 ± 0.11 |
| 24 months | 38.31 ± 0.21 | 305.19 ± 2.33 | 20.38 ± 0.09 |
Publisher’s Note: MDPI stays neutral with regard to jurisdictional claims in published maps and institutional affiliations. |
© 2021 by the authors. Licensee MDPI, Basel, Switzerland. This article is an open access article distributed under the terms and conditions of the Creative Commons Attribution (CC BY) license (https://creativecommons.org/licenses/by/4.0/).
Share and Cite
Oyekanmi, A.A.; Kumar, U.S.U.; H. P. S., A.K.; Olaiya, N.G.; Amirul, A.A.; Rahman, A.A.; Nuryawan, A.; Abdullah, C.K.; Rizal, S. Functional Properties of Antimicrobial Neem Leaves Extract Based Macroalgae Biofilms for Potential Use as Active Dry Packaging Applications. Polymers 2021, 13, 1664. https://doi.org/10.3390/polym13101664
Oyekanmi AA, Kumar USU, H. P. S. AK, Olaiya NG, Amirul AA, Rahman AA, Nuryawan A, Abdullah CK, Rizal S. Functional Properties of Antimicrobial Neem Leaves Extract Based Macroalgae Biofilms for Potential Use as Active Dry Packaging Applications. Polymers. 2021; 13(10):1664. https://doi.org/10.3390/polym13101664
Chicago/Turabian StyleOyekanmi, A. A., U. Seeta Uthaya Kumar, Abdul Khalil H. P. S., N. G. Olaiya, A. A. Amirul, A. A. Rahman, Arif Nuryawan, C. K. Abdullah, and Samsul Rizal. 2021. "Functional Properties of Antimicrobial Neem Leaves Extract Based Macroalgae Biofilms for Potential Use as Active Dry Packaging Applications" Polymers 13, no. 10: 1664. https://doi.org/10.3390/polym13101664
APA StyleOyekanmi, A. A., Kumar, U. S. U., H. P. S., A. K., Olaiya, N. G., Amirul, A. A., Rahman, A. A., Nuryawan, A., Abdullah, C. K., & Rizal, S. (2021). Functional Properties of Antimicrobial Neem Leaves Extract Based Macroalgae Biofilms for Potential Use as Active Dry Packaging Applications. Polymers, 13(10), 1664. https://doi.org/10.3390/polym13101664

